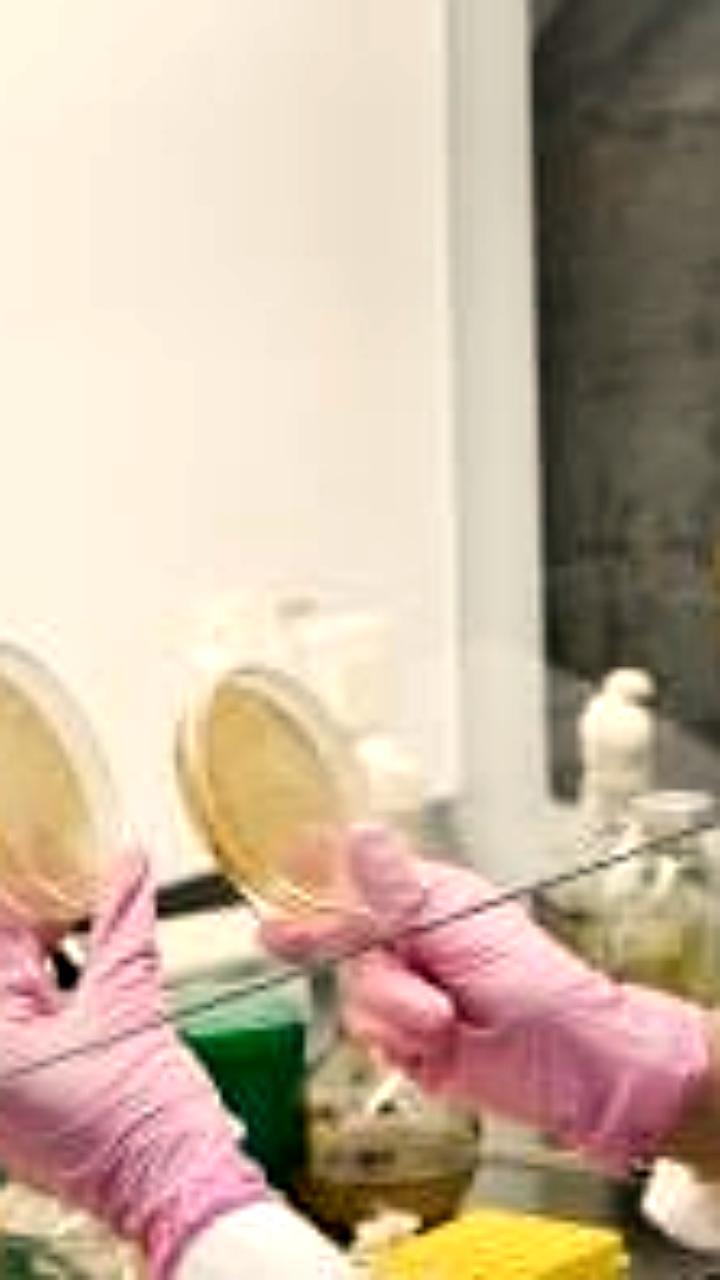

21 ноября, 06:40
Томские учёные передают 20 штаммов лактобактерий для производства кисломолочной продукции


ТГУ | Томский государственный университет
Микробиологи ТГУ передают 20 «чистых» штаммов лактобактерий Угличской биофабрики. Полезные микроорганизмы могут быть использованы в производстве сыров и других кисломолочных продуктов. Заведующая кафедрой физиологии растений, биотехнологии и биоинформатики БИ ТГУ Ольга Карначук: — В России сейчас довольно сложная ситуация с заквасками для сыров, сметаны, творога, йогуртов. Отечественные коллекции промышленных микроорганизмов, которые создавались в СССР, частично утрачены и не отвечают требованиям. Сейчас перед учёными и промышленниками стоит задача формирования крупных отечественных коллекций, которые обеспечат независимость пищевой промышленности от импорта. Подробнее ———————————
Наука331 день назад


ТВ2. Новости Томска и Сибири
Импортзаместить «кисломолочные» бактерии помогут российской пищевой промышленности ученые ТГУ Микробиологи ТГУ передали «Угличской биофабрике» 20 «чистых» штаммов лактобактерий, которые можно будет использовать для производства сыров и других кисломолочных продуктов. На поиск этих штаммов у томичей ушло три года. «В России сейчас довольно сложная ситуация с заквасками для сыров, сметаны, творога, йогуртов, — пояснила заведующая кафедрой физиологии растений, биотехнологии и биоинформатики БИ ТГУ Ольга Карначук. — Отечественные коллекции промышленных микроорганизмов, которые создавались в СССР, частично утрачены и не отвечают современным международным требованиям, а западные коллекции становятся недоступными в связи с уходом зарубежных производителей с российского рынка». Сейчас перед учеными и промышленниками стоит задача — сформировать крупные отечественные коллекции микроорганизмов, чтобы добиться независимости российской пищевой промышленности от импорта. Для понимания, почему это необходимо: сейчас российские коллекции исчисляются всего тысячами штаммов, в то время как только у одного крупнейшего производителя заквасок, датской компании Chr. Hansen — порядка 50 000 штаммов. В 2023 году в ярославском Угличе началось строительство биофабрики — предприятия по производству бактериальных заквасок и концентратов для пищевой промышленности. «Планируется, что уже к середине 2025 года предприятие выйдет на 50% проектной мощности», — говорится на сайте «Угличской биофабрики». «Задача по созданию больших российских биобанков промышленных микроорганизмов вполне решаема, – считает директор "Угличской биофабрики" Дмитрий Фурсаев. — Это требует значительных усилий со стороны университетов и предприятий. Не менее важный вопрос — строительство новых перерабатывающих производств, внедрение современных технологий и подготовка кадров для этих предприятий».
Наука330 дней назад


Наука.рф
За сквашивание молока, вкус и запах сыра, кефира и других кисломолочных продуктов отвечают особые микроорганизмы — лактобактерии. Российские учёные предложили обеспечить промышленность бактериями, не обладающими устойчивостью к антибиотикам. Дело в том, что продукты, в которых содержатся микроорганизмы с резистентностью, могут привести к её появлению и у людей. Тогда при серьёзных заболеваниях антибиотики не помогут или дадут неполный эффект. Микробиологи Томского госуниверситета три года искали и собирали «чистые» штаммы лактобактерий, не обладающих антибиотикорезистентностью. Коллекцию из 20 таких штаммов они обещают до конца год передать производителям кисломолочной продукции. «Сейчас перед учёными и промышленниками стоит задача формирования крупных отечественных коллекций, которые обеспечат независимость пищевой промышленности от импорта», — пояснила завкафедрой биотехнологии и биоинформатики БИ ТГУ Ольга Карначук. Наука.рф #десятилетиенауки
Наука331 день назад

ВЕСТИ-ТОМСК
Микробиологи ТГУ вносят вклад в расширение отечественной коллекции молочнокислых микроорганизмов До конца этого года ученые Томского госуниверситета передадут Угличской биофабрике 20 чистых штаммов лактобактерий, которые были получены в рамках большого проекта по борьбе с устойчивостью микробов к антибиотикам. Их будут использовать в производстве сыров и других кисломолочных продуктов. Сотрудничество университета и фабрики способствует импортозамещению в сфере пищевой промышленности. Подписаться Прислать новость
Наука329 дней назад


Естественный интеллект: новости науки и техники
В ТГУ создали штаммы бактерий для сыров без устойчивости к антибиотикам Двадцать новых штаммов лактобактерий без устойчивости к антибиотикам, разработанных микробиологами Томского государственного университета ТГУ , будут переданы в рамках сотрудничества предприятию ООО «Угличская биофабрика», сообщает пресс-служба вуза. Разработка «чистых» штаммов лактобактерий, которые могут быть использованы в производстве сыров и других кисломолочных продуктов, велась три года. Заведующая кафедрой физиологии растений, биотехнологии и биоинформатики Биологического института БИ ТГУ Ольга Карначук пояснила: «В России сейчас довольно сложная ситуация с заквасками для сыров, сметаны, творога, йогуртов и т. д. Отечественные коллекции промышленных микроорганизмов, которые создавались в СССР, частично утрачены и не отвечают современным международным требованиям, а западные коллекции становятся недоступными в связи с уходом зарубежных производителей с российского рынка». Подробнее
Наука327 дней назад
Похожие новости



+6



+1









+1



Соглашение о научном сотрудничестве между курортом Солёные озёра и Оренбургским федеральным исследовательским центром УрО РАН
Наука
23 часа назад




Отмена субсидий угрожает крупным производителям молока Татарстана потерей 500 млн рублей в год
Политика
33 минуты назад




Нобелевские премии 2023: открытия в физике, химии и медицине
Наука
1 день назад

Препарат Океанида от Роснефти получил одобрение экологической экспертизы
Наука
9 часов назад



С 1 марта 2026 года вводится обязательная маркировка зерновых хлопьев для завтрака
Политика
1 день назад




В Зеленограде откроется новое производство внутривенного питания
Наука
30 минут назад

